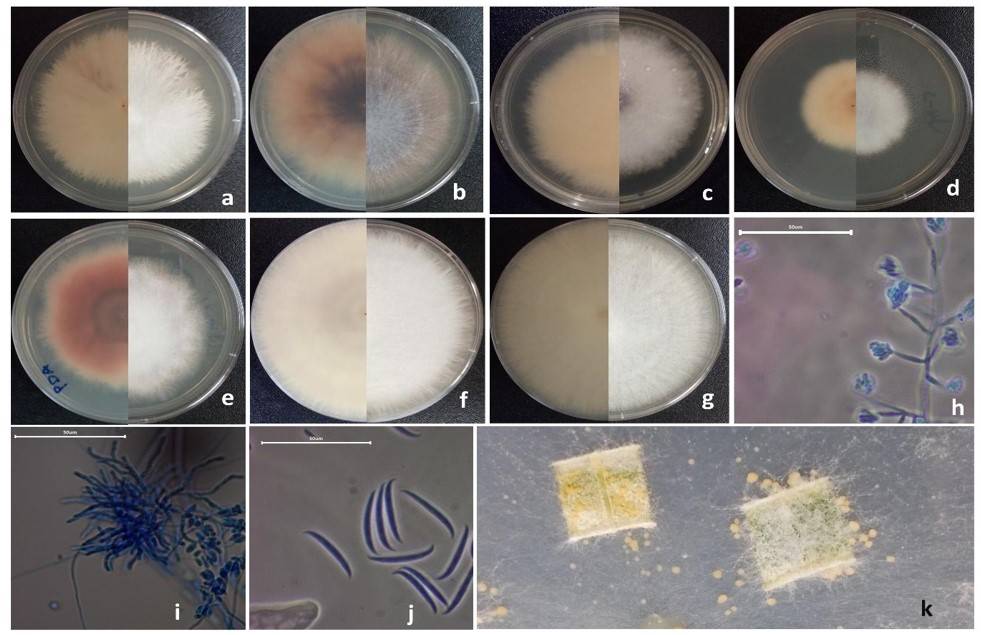

Introducción
El cultivo de plántulas en vivero es una de las actividades más relevantes de los programas de reforestación. Para considerar una plántula apta para dichos programas, la Comisión Nacional Forestal (CONAFOR) considera ciertas características que deben cumplir con la norma mexicana NMX-AA-170-SCFI-2016 (Secretaría de Economía, 2016). En Durango, para el año 2018 se produjeron 8 291 544 plantas y se reforestaron 4 680.80 ha (CONAFOR 2019a, 2019b) que correspondió a 9.6% de la superficie y a 11% de la planta producida en el país, por lo que lo sitúa como el estado con mayor cantidad de planta producida y superficie reforestada.
En un estudio realizado por Prieto et al. (2009), reportaron que el 100% de los viveros estudiados presentaron problemas provocados por hongos fitopatógenos causantes de la enfermedad del almácigo, también conocida damping-off.
La enfermedad se presenta de dos formas: la primera denominada pre-emergente, donde se ven afectadas las semillas en proceso de germinación y el pos-emergente que ataca plántulas jóvenes que no han lignificado del tallo (Landis et al., 1989; Dar et al., 2011). Esta enfermedad, se presentó frecuentemente en semillas y plántulas de muchas especies forestales y de otros cultivos y es causada por un complejo de microorganismos el cual incluye oomicetos y hongos que ven favorecido su desarrollo principalmente por condiciones de alta humedad (Fajardo-Mejía et al., 2016).
Los géneros más comunes de hongos que causan el problema de damping-off son Fusarium y Rhizoctonia, de los cuales Fusarium es el más importante por su ubicuidad (Dumroese y James, 2005). Una de las principales metas de la fitopatología es lograr el conocimiento de los agentes que causan enfermedades en las plantas cultivadas y mediante la aplicación de técnicas y herramientas adecuadas reducir la severidad e incidencia de las enfermedades y así disminuir las pérdidas provocadas por éstas (Solano-Bonilla y Brenes-Chacón, 2012).
El objetivo del presente estudio fue aislar hongos de plántulas de pino con síntomas de la enfermedad en viveros forestales del estado de Durango, para identificarlos y caracterizarlos utilizando microscopia óptica de campo claro; así como, mediante el uso de pruebas de patogenicidad y determinar el daño ocasionado a la planta, la función de supervivencia y el ajuste a modelos epidemiológicos.
Materiales y métodos
Se realizó un muestreo en cinco viveros distribuidos en el estado de Durango en septiembre de 2018. Vivero INIFAP (23° 59’ 23.2’’ latitud norte y 104° 37’ 26.2’’ longitud oeste 1879 msnm), vivero General Francisco Villa (25° 58’ 19.7’’ latitud norte y 104° 35’ 51.6’’ longitud oeste 1 878 msnm), vivero de la Facultad de Ciencias Forestales de la Universidad Juárez del Estado de Durango (24° 00’ 48.3’’ latitud norte y 104° 41’ 03.2’’ longitud oeste 1 899 msnm) y dos viveros ubicados en el municipio de Santiago Papasquiaro: vivero General Emiliano Zapata (25° 03’ 40’’ latitud norte y 105° 26’ 17’’ longitud oeste 1 756 msnm) y vivero San Nicolás (24° 56’ 57’’ latitud norte y 105° 25’ 02.8’’ latitud oeste 1 806 msnm).
El muestreo consistió en extraer plántulas de 45 días de edad aproximada con síntomas de damping-off, se homogenizaron con solución amortiguadora de fosfatos pH 7.2, se realizaron diluciones decimales seriadas y de las diluciones 10-5 y 10-6 y se sembraron con la técnica de extensión en placa en medio de cultivo papa dextrosa agar (PDA) por duplicado. Las placas se incubaron a 28 °C por siete días en una incubadora (Quincylab® 12-140). Al terminar el periodo de incubación, se registró el aspecto de las colonias fúngicas (Gabrekiristos et al., 2020). Para conseguir el cultivo axénico, se realizaron transferencias consecutivas por punta de hifa en PDA.
Para observar las características microscópicas generales, cada aislado se cultivó con la técnica de microcultivo en PDA (Harris, 1986) y la forma de inoculación que propuso Rosana et al. (2014). Las observaciones microscópicas se realizaron con el objetivo 40x del microscopio (Leica® CME) y se midieron los microconidios con el software AmScope® versión 3.7 (calibrado con un micrómetro Euromex® AE 1110 con retícula de 0.01 mm). La identificación a nivel de complejo de especies de cada aislado fúngico se realizó con las descripciones y claves reportadas por Leslie y Summerell (2006).
Para observar las características microscopias específicas de los aislados, se prepararon cultivos monospóricos con la adaptación de la técnica aplicada por Obanor et al. (2013). Finalmente se realizaron transferencias de discos miceliales del borde de una colonia aislada a placas Petri con PDA e incubadas a temperatura ambiente durante siete días con luz continua (Nelson et al., 1983), en medio de cultivo SNA, e incubadas a 25 °C durante siete días (Leslie y Summerell, 2006) y también en medio hojas de clavel agar (CLA) preparado con la técnica descrita por Peluola et al. (2020) e incubadas a 25 °C durante siete días, con un fotoperiodo de 12 h de luz ultravioleta (365 nm) y 12 h de luz blanca (Britz et al., 2001).
Se registró la forma y tamaño de microconidios, macroconidios, forma de la célula apical, forma de la célula base, largo, ancho, curvatura dorsiventral y número de septos. Se tomaron 100 mediciones de largo y ancho de macroconidios y microconidios producidos por cada aislado como lo sugieren Rentería-Martínez et al. (2019); Robles-Yerena et al. (2016); García-Díaz et al. (2017).
Se llevó a cabo un ensayo en vivero para verificar la patogenicidad de los aislados (postulados de Koch). El experimento se desarrolló en el vivero forestal del INIFAP-Durango. Se utilizaron contenedores de polietileno rígido de 98 cavidades llenados con una mezcla compuesta por 50% de peat moss, 25% de perlita expandida y 25% de vermiculita con fertilizante de lenta liberación (8 meses) Osmocote® de formulación 18-6-12 (N-P-K) a una dosis de 4 g L-1 de sustrato preparado.
El tamaño de la unidad experimental fue de 18 cavidades, se evaluaron dos tratamientos (testigo absoluto y tratamiento inoculado) con cinco repeticiones y el diseño aplicado fue completamente al azar. Cada aislado fúngico se evaluó sobre la especie de pino de la cual se obtuvo originalmente. Previo a su siembra, la semilla recibió un tratamiento de flotación, se desinfestó en una solución de hipoclorito de sodio comercial y enjuague con agua destilada estéril y se dejó secar durante 10 min (Aoudou et al., 2012).
El testigo absoluto se sembró después de su preparación pre-germinativa colocando una semilla a 1 cm de profundidad en cada cavidad y se tapó con mezcla de sustrato. En lo que respecta a la semilla para el tratamiento inoculado, la inoculación se llevó a cabo siguiendo la metodología de Morales-Rodríguez et al. (2018) con algunas modificaciones. Después se depositando una semilla por cavidad a 1 cm de profundidad y se tapó con mezcla de sustrato.
Se hicieron conteos diarios de germinación a partir de la primera plántula emergida y hasta cumplir 50 días después de la siembra (dds). Las variables evaluadas fueron: porcentaje de germinación y el índice de germinación, con las siguientes fórmulas (González-Zertuche y Orozco-Segovia, 1996).
Donde: PG= porcentaje de germinación; sg= semillas germinadas; ss= semillas sembradas; IG= índice de germinación; ni= número de semillas germinadas al día i, ti= número de días después de la siembra y N= total de semillas sembradas; VG= velocidad de germinación; y t= tiempo de germinación desde la siembra hasta la germinación de la última semilla. También, a partir de que germinó la primera semilla, se realizaron conteos diarios de plántula muerta por damping-off durante 180 días. Estas plántulas dañadas se extrajeron de la cavidad de crecimiento para su traslado al laboratorio y trasferencia a medio de cultivo PDA.
De las colonias desarrolladas se transfirieron a placas preparadas para microcultivo con la metodología de Harris (1986); Rosana et al. (2014) y se incubaron a 25 °C durante seis días. Se realizaron observaciones al microscopio para corroborar el crecimiento y comprobar los postulados de Koch y así determinar el porcentaje de daño en plántulas.
Los datos de germinación y daño fueron sometidos a un análisis estadístico mediante la prueba de Wilcoxon, se realizó la prueba Log-Rank a partir de las curvas de Kaplan-Meier para determinar las diferencias de supervivencia entre los tratamientos a los 180 dds. Con los datos del porcentaje de daño de los aislados que presentaron diferencias significativas respecto al testigo, se determinaron curvas de progreso de la enfermedad y su ajuste a modelos epidemiológicos, Gompertz, logístico, exponencial y monomolecular (Campbell y Madden 1990), para definir los parámetros de la ecuación y definir la incidencia de la enfermedad. El análisis estadístico se realizó con ayuda del software InfoStat® versión 2017 (Di Rienzo et al., 2017) y los gráficos en SigmaPlot® versión 10.0.
Resultados y discusión
Se encontraron plántulas de estas especies con la sintomatología característica de damping-off: postradas con pérdida de turgencia generalizada, constricción y necrosis en el cuello. De estas plántulas, se obtuvieron aislados fúngicos, y siete de los aislamientos mostraron macroscópicamente la morfología colonial del género Fusarium: superficie seca y el micelio semejante al algodón y producción de pigmentos rosa pálido a rosa violáceo (Nelson et al., 1983; Watanabe, 2010).
Los aislados obtenidos de las especies cultivadas durante el muestreo del presente estudio coinciden con los hallazgos de Menkis et al. (2006) en los cuales encontraron hongos del género Fusarium colonizando raíces de plántulas de Pinus silvestris y Picea abies y que no encontraron especies de los géneros Rhizoctonia, ni oomicetos de los géneros Phytium y Phytophthora.
Se presentaron variaciones entre estos aislados como elevación de la colonia (plana, umbonada, elevada y convexa) y la disposición de las hifas en el micelio (inclinadas, levemente inclinadas y erectas). Se optó por separar a estos aislados fúngicos y asignarles un ID, de acuerdo con estas diferencias y la especie de pino de la cual fueron aislados. El aislado 1 fue obtenido de Pinus engelmannii (FPe1), el aislado 2 de Pinus engelmannii (FPe2), el aislado 3 de Pinus engelmannii (FPe3), el aislado 4 de Pinus durangensis (FPd1), el aislado 5 de Pinus arizonica (FPa1), el aislado 6 de Pinus arizonica (FPa2), y el aislado 7 de Pinus cooperi (FPc1).
Al cultivar los aislados en medio SNA, se observó la formación de microconidios de forma ovoide sin septos, y estos producidos en falsas cabezas sobre monofialides y polifiálides (Figura 1). El tamaño promedio de los microconidios fue de 6.54 µm de largo por 2.13 µm de ancho. De estos aislados destacan FPe1, FPe3 y FPd1 por el desarrollo de hifas enrolladas que no se desarrollaron en los otros aislados. Los aislados FPe2, FPa1, FPa2 y FPc1, produjeron clamidosporas terminales e intercalares al ser cultivados en PDA, detalle que no se presentó en los otros aislados.
Figura 1 a) aislado 1; b) aislado 2; c) aislado 3; d) aislado 4; e) aislado 5; f) aislado 6; g) aislado; 7 del inciso a al g, la parte izquierda es el reverso y la derecha el anverso de la placa; h) coniodióforos producidos por el aislado 3 en medio SNA; i) hifas enrolladas producidas por el aislado 4 en medio SNA; j) macroconidios producidos por el aislado 6; barra de escala 50 µm; y k) esporodoquios producidos por el aislado 7.
En el medio CLA tres aislados produjeron esporodoquios de color amarillo a naranja (FPa1, FPa2 y FPc1), se visualizaron macroconidios fusiformes, con curvatura dorsiventral moderada (Figura 1), con la célula base en forma de pie y la célula apical en forma curvada, con dos y tres septos en FPa1, FPa2, y tres a cuatro septos en FPc1. El tamaño de macroconidios de FPa1, FPa2 fue de 37.62 µm de largo por 3.3 µm de ancho, en FPc1 el tamaño de macroconidios fue de 23.63 µm de largo por 2.53 µm de ancho.
Dadas las características macroscópicas y microscópicas de los aislados obtenidos y sus semejanzas morfológicas con dos complejos de especies del Fusarium mencionadas en el manual de laboratorio de Fusarium (Leslie y Summerell, 2006), se sugirió que los aislados FPe1, FPe3 y FPd1 correspondieron con las características del complejo de especies de Fusarium fujikuroi y para los aislados FPe2, FPa1, FPa2 y FPc1 correspondieron al complejo de especies de Fusarium oxysporum.
Los estudios reportados por Robles-Yerena et al. (2016); García-Díaz et al. (2018) son los que se han realizado en México sobre el hallazgo de especies de Fusarium que producen problemas de marchitamiento en plántulas de pino en etapa de vivero y algunas son semejantes a algunos aislados de la presente investigación.
Después de 1998 aumentó la descripción de nuevas especies, a partir del reconocimiento de que varias morfoespecies tradicionales, son complejos de especies compuestos por muchas especies (Sumemerell y Leslie, 2011); por ejemplo, el complejo de especies de F. fujikuroi contiene 65 especies aceptadas e incluye algunas especies que solamente se pueden identificar en función de su inferencia filogenética mediante biología molecular (Yilmaz et al., 2021), además como mencionan Crous et al. (2021) otros linajes de Nectriaceae producen conidios con morfología similar a Fusarium y por ello el reconocimiento de especies de Fusarium únicamente con caracteres morfológicos es muy complicado, es por esto que en el presente trabajo únicamente se sugieren concordancias en la morfología de los aislados obtenidos a los complejos F. fujikuroi (FFSC) y F. oxysporum (FOSC).
En la mayoría de los tratamientos inoculados con los aislados no presentaron diferencias respecto al testigo en las variables de germinación, índice de germinación y velocidad de germinación, por lo que se confirma que no provocaron daño preemergente y en ellos se presentó una germinación promedio comprendida entre 80 a 95%, solo en la especie P. arizonica, aunque no se presentaron daños en preemergencia respecto al testigo, la germinación promedio fue de 34 a 45%, posiblemente porque el cultivo de esa especie en particular se realiza en el norte del estado de Durango, ubicación de latitud más septentrional que en el lugar donde se desarrolló el experimento en vivero.
En la germinación solo se presentó diferencia en un tratamiento inoculado en la especie P. engelmannii (FPe3). En esta, el porcentaje de germinación en el testigo fue de 90% y en el inoculado fue de 63%; es decir, disminuyó en 27% la germinación, indicando que este aislado fue el único que provoco daño preemergente y se confirmó con los resultados obtenidos en el análisis de índice germinativo ya que también presentó diferencias significativas en esta variable. Solo en P. durangensis se presentaron diferencias en la variable velocidad de germinación entre el testigo y el tratamiento inoculado.
La acumulación de plántulas dañadas se concentró del día 13 dds al día 40 dds (semana 2 a la semana 7). En la variable daño, los tratamientos inoculados con aislados que no presentaron diferencias respeto el testigo fueron FPe1, FPe2 y FPc1, de manera que se consideran como los menos virulentos.
Por otro lado, los tratamientos inoculados con los aislados que provocaron daño significativo respecto al testigo, es decir mayor porcentaje de daño postemergente en orden ascendente fueron: FPa1 (32.2%), FPd1(60.7%), FPa2 (61.1%) y FPe 3 (100%). El aislado FPe3 (aislado 3), se considera como el más virulento, ya que en el menor tiempo acumuló la mayor cantidad de plántulas dañadas (Figura 2).

Figura 2 Curvas de supervivencia Kaplan-Meier de los aislados de Fusarium que presentaron diferencias significativas respecto al testigo.
Estos resultados coinciden con los descritos en otros estudios que han analizado patogénesis de Fusarium en otras especies de pino como los de Davydenko et al. (2018) quienes encontraron que F. circinatum causó la muerte de casi todas las plántulas de distintas procedencias de Pinus sylvestris y F oxysporum, provocó un daño considerable de 62-66% para el día 21 después de la inoculación.
Por su parte, Mateos et al. (2017), encontraron que F oxysporum presentó un mayor índice de daño comparado con F. verticillioides en Pinus sylvestris y Pinus pinea. Por otro lado, Lazreg et al. (2014) encontraron que F. redolens y F. solani causan mayor daño en plántulas de pino seguidos por F. tricinctum y F. oxysporum en Pinus halepensis.
En este ensayo, las primeras semanas fueron clave para el desarrollo del patógeno y la muerte de la plántula. Este período es el crítico para llevar a cabo los tratamientos fitosanitarios preventivos y curativos necesarios para frenar el desarrollo de la enfermedad. Esto se relaciona con lo expresado por Davydenko et al. (2018) quienes indicaron que los invernaderos que poseen planta infectada con F. circinatum son el primer punto de entrada de la enfermedad y son fuente de transmisión del cancro resinoso del pino en plantaciones forestales comerciales.
El modelo epidemiológico que presentó mejor ajuste para el comportamiento del aislado FPe3 fue el Gompertz, representado por la expresión daño= alfa*exp(-beta*exp(-gamma*DDS)), en este, los parámetros realizaron una contribución significativa (p< 0.05) y sus parámetros fueron alfa 98.36, beta 15.36 y gama 0.15. También para el aislado FPd1 el mejor ajuste lo presentó el modelo Gompertz y sus parámetros fueron alfa 55.78, beta 7.27 y gama 0.08.
Por otro lado, para los aislamientos obtenidos de P. arizonica es decir FPa1 y FPa2, el modelo que presentó el mejor ajuste fue el modelo monomolecular representado con la expresión daño= alfa*(1-beta*exp(-gamma*DDS)), para FPa1 los parámetros fueron alfa 55.78, beta 7.27 y gama 0.08, y FPa2 los parámetros fueron alfa 55.78, beta 7.27 y gama 0.08.
En este contexto, Ocamb et al. (2002) mencionaron que la variación en las poblaciones de Fusarium, puede ser influida durante la manipulación y la siembra y éste hongo puede ser introducido durante el almacenamiento o el manejo de la semilla y recomienda realizar pruebas de patogenicidad para conocer reamente el potencial de daño de las especies de Fusarium aisladas de plántulas.
Conclusiones
Se logró aislar hongos a partir de plántulas con síntomas de damping-off en viveros del estado de Durango y estos correspondieron a aislados del género Fusarium de los complejos de especie F. fujikuroi y F. oxysporum de acuerdo con sus caracteres morfológicos. Los aislados más virulentos fueron obtenidos de Pinus engelmannii, P. durangensis y que presentaron ajuste al modelo Gompertz, mientras que los aislados obtenidos de P. arizonica tuvieron mejor ajuste al modelo monomolecular. Es necesario, realizar identificación molecular de estos aislados para conocer a detalle las especies de Fusarium que causan el damping-off en las plántulas de pino que se producen en los viveros del estado de Durango.










texto em 


